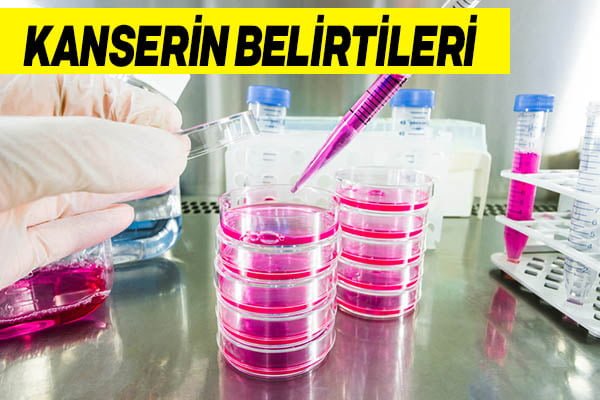
kanserin belirtileri

- Kanser Olup Olmadığınızı Nasıl Anlarsınız?
- Aniden ortaya çıkan nefes alma problemi
- Çok çabuk ateşlenip, hasta hissediyorsanız
- Yutkunurken zorlanıyorsanız ( ki bu çoğu zaman pastil alınarak geçiştirilir)
- Lenf beziniz sizi rahatsız ediyorsa
- Vücutta morarmalar varsa ve kanamalarınız geç duruyorsa
- Kasıklarınızda ve karnınızda ağrılar başladıysa
- Kilo alıp vermelerinizde hızlanma oluyorsa
- Dışkı kontrolü yaptığınızda kan görüyorsanız
- Beslenmenizde bir sorun olmamasına rağmen mide ağrıları yaşıyorsanız
- Göğüs ucunuzda akıntılar varsa kesinlikle doktorunuzla görüşün
- Regl dönemleri uzamaya ve ağrılar artmaya başladıysa
- Tırnak şekil bozuklukları farkettiyseniz
- İştah problemi yaşıyor ve kendinizi aç hissetmiyorsanız
En sinsi hastalık olarak bilinen ve farketmesi güç olan kanser çok dikkatli edilmesi gereken bir hastalıktır. En büyük temennimiz adını anmak bile istemediğimiz bu hastalığın kesin tedavisinin bulunması olsa da günümüzde bu hastalık için erken teşhis hâlâ çok önemli. Hazırsanız artık kanserin en sinsi belirtilerine geçebiliriz…
Kanser Olup Olmadığınızı Nasıl Anlarsınız?
Başlamadan önce bu belirtilerin sadece bir varsayım olduğunu, asıl teşhisin doktor kontrolünden sonra olabileceğini unutmayın.
Aniden ortaya çıkan nefes alma problemi

Çok çabuk ateşlenip, hasta hissediyorsanız
Yutkunurken zorlanıyorsanız ( ki bu çoğu zaman pastil alınarak geçiştirilir)
Lenf beziniz sizi rahatsız ediyorsa

Vücutta morarmalar varsa ve kanamalarınız geç duruyorsa
Kasıklarınızda ve karnınızda ağrılar başladıysa
Genellikle dönemsel ağrılar ile karıştırılır. Eğer 2 ya da 3 kez mevcut döneminizin dışında bu tür ağrılar yaşıyorsanız doktora görünmeniz içinizin rahat etmesini sağlayacaktır.
Kilo alıp vermelerinizde hızlanma oluyorsa
Dışkı kontrolü yaptığınızda kan görüyorsanız
Beslenmenizde bir sorun olmamasına rağmen mide ağrıları yaşıyorsanız

Göğüs ucunuzda akıntılar varsa kesinlikle doktorunuzla görüşün
Regl dönemleri uzamaya ve ağrılar artmaya başladıysa
Tırnak şekil bozuklukları farkettiyseniz

Bu belirti vitamin eksikliğine bağlansa da aslında öyle olmayabilir.
İştah problemi yaşıyor ve kendinizi aç hissetmiyorsanız
Bu tarz belirtiler kanserin başlangıç belirtileri olabilirler. O yüzden muhakkak bir doktorla görüşün ve şikayetlerinizi anlatın. Unutmamak gerekir ki her hastalıkta olduğu gibi kanserde de ilk teşhis her zaman çok önemlidir.
